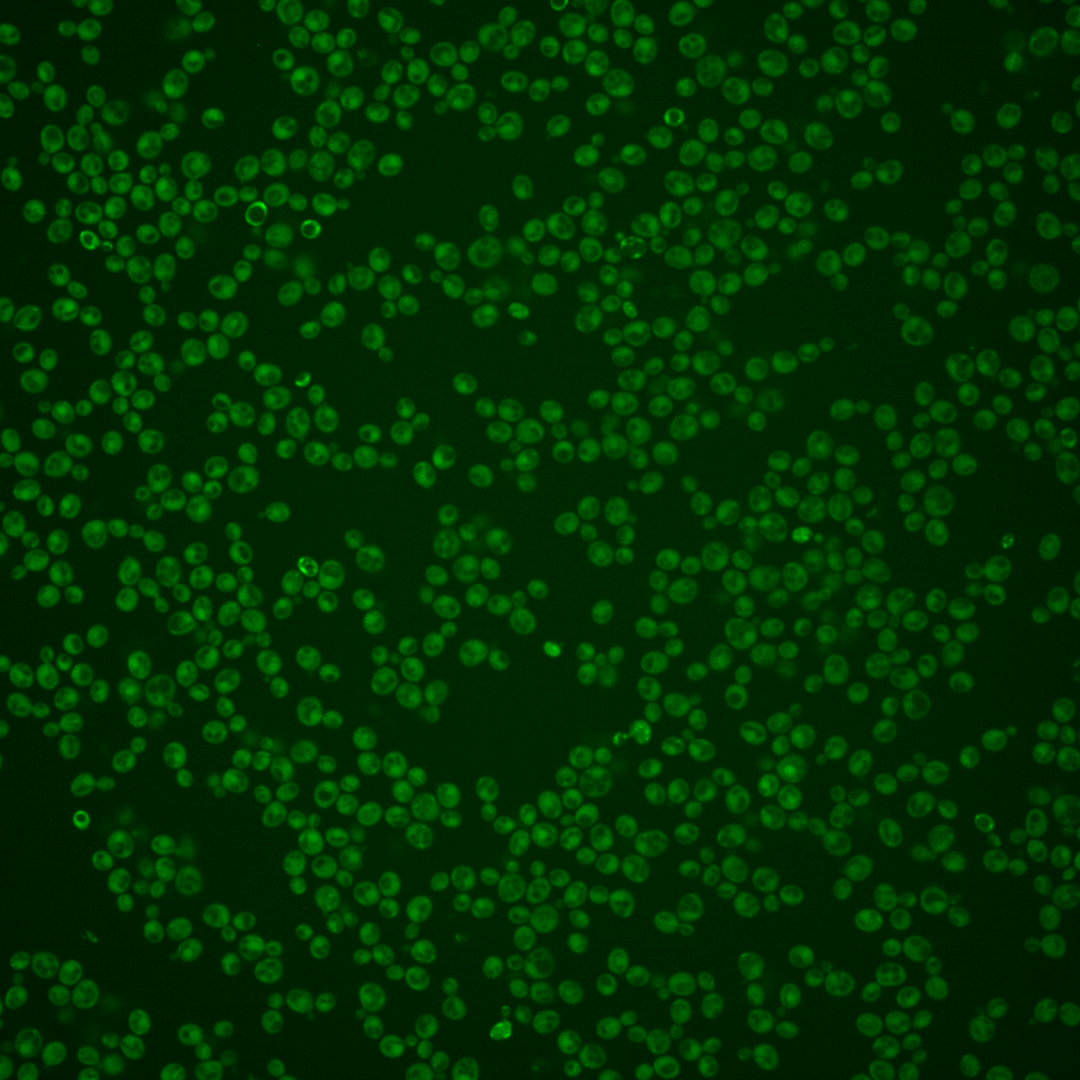
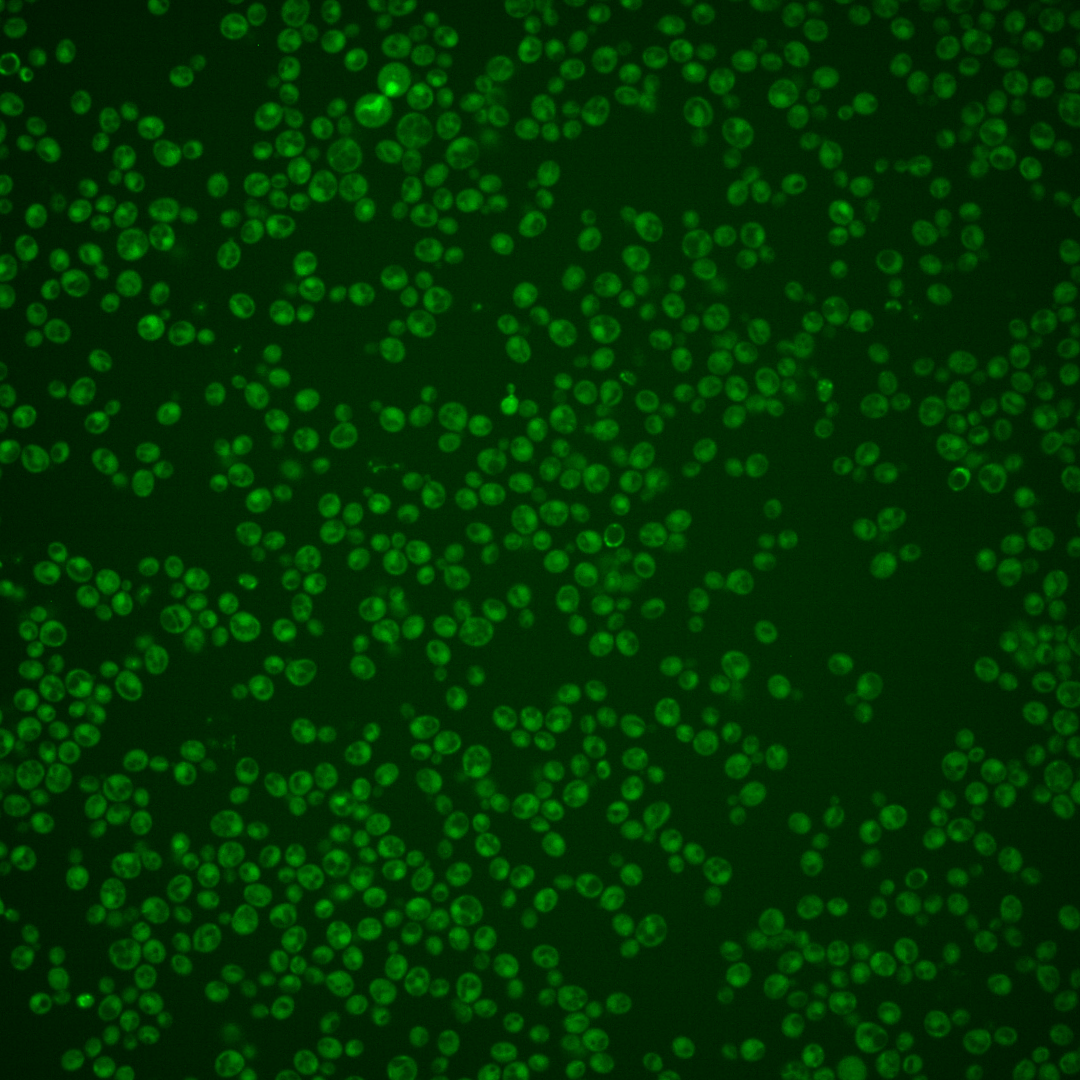
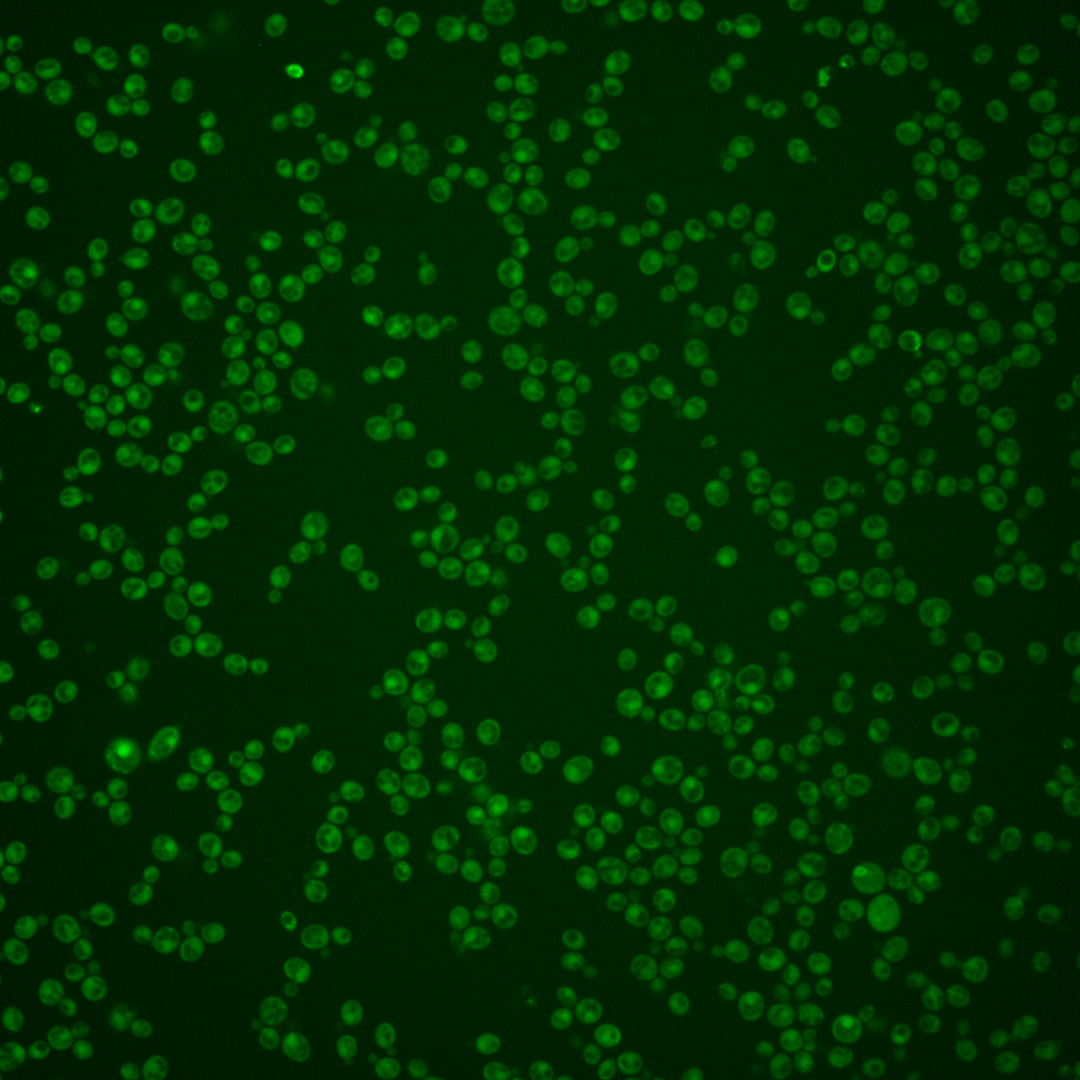
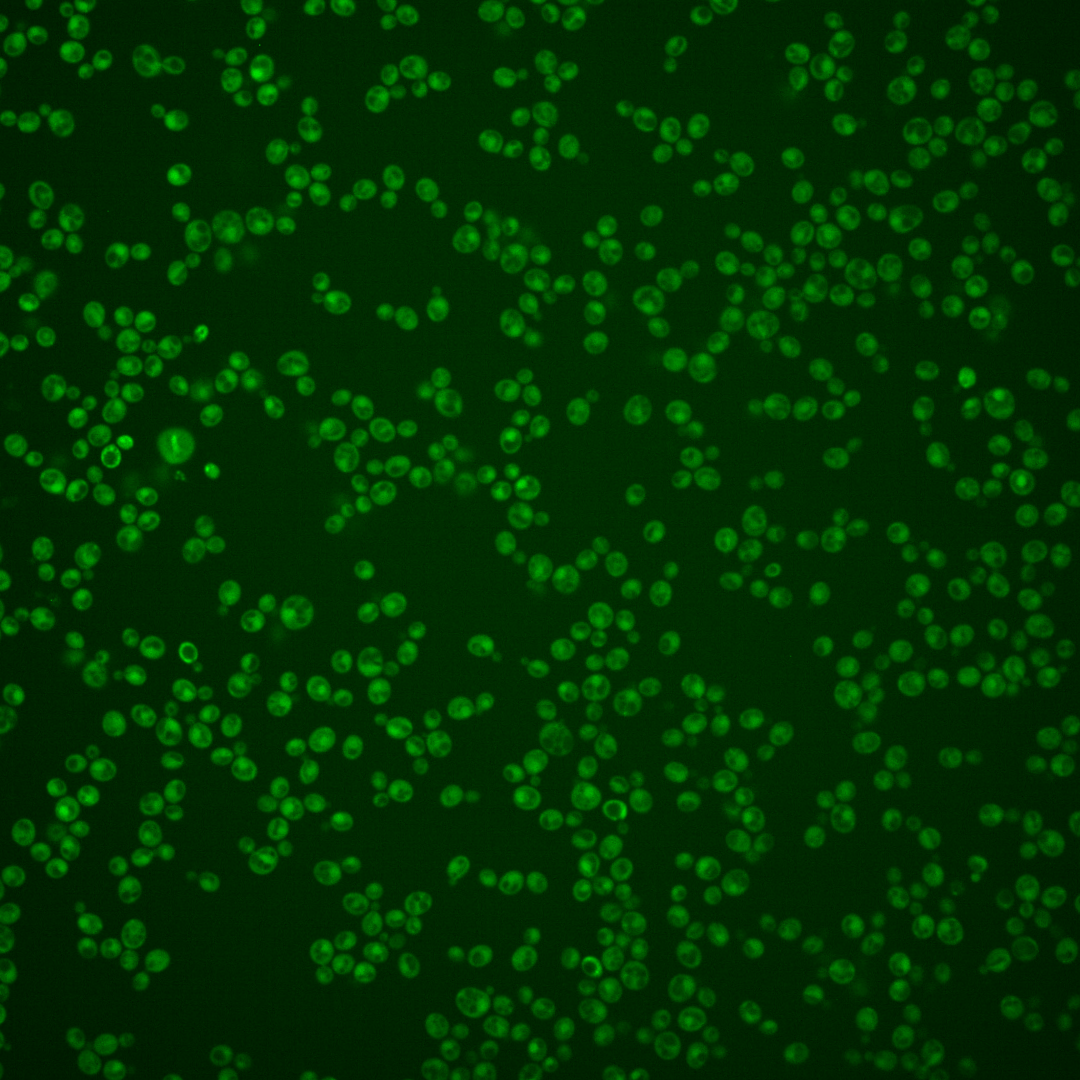
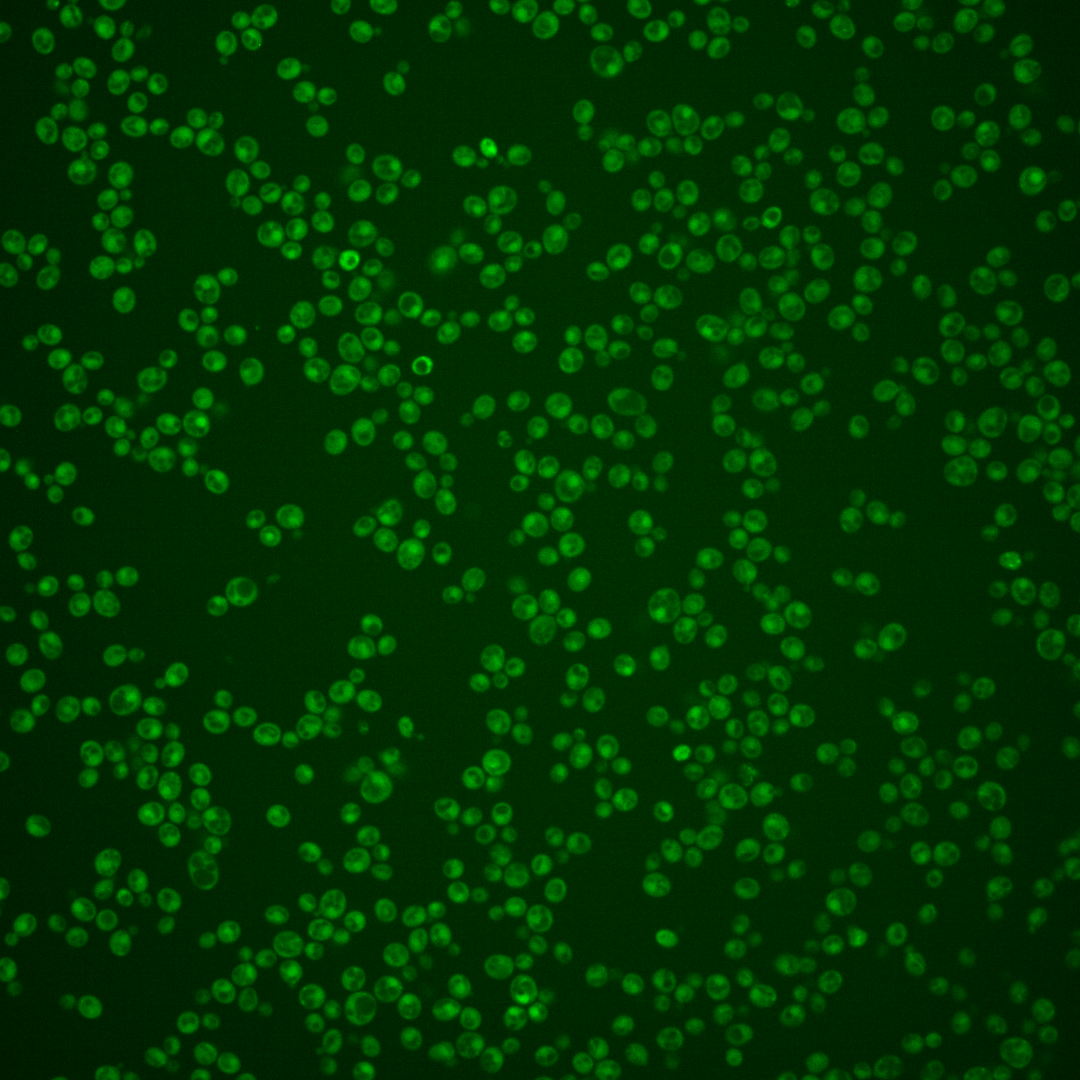
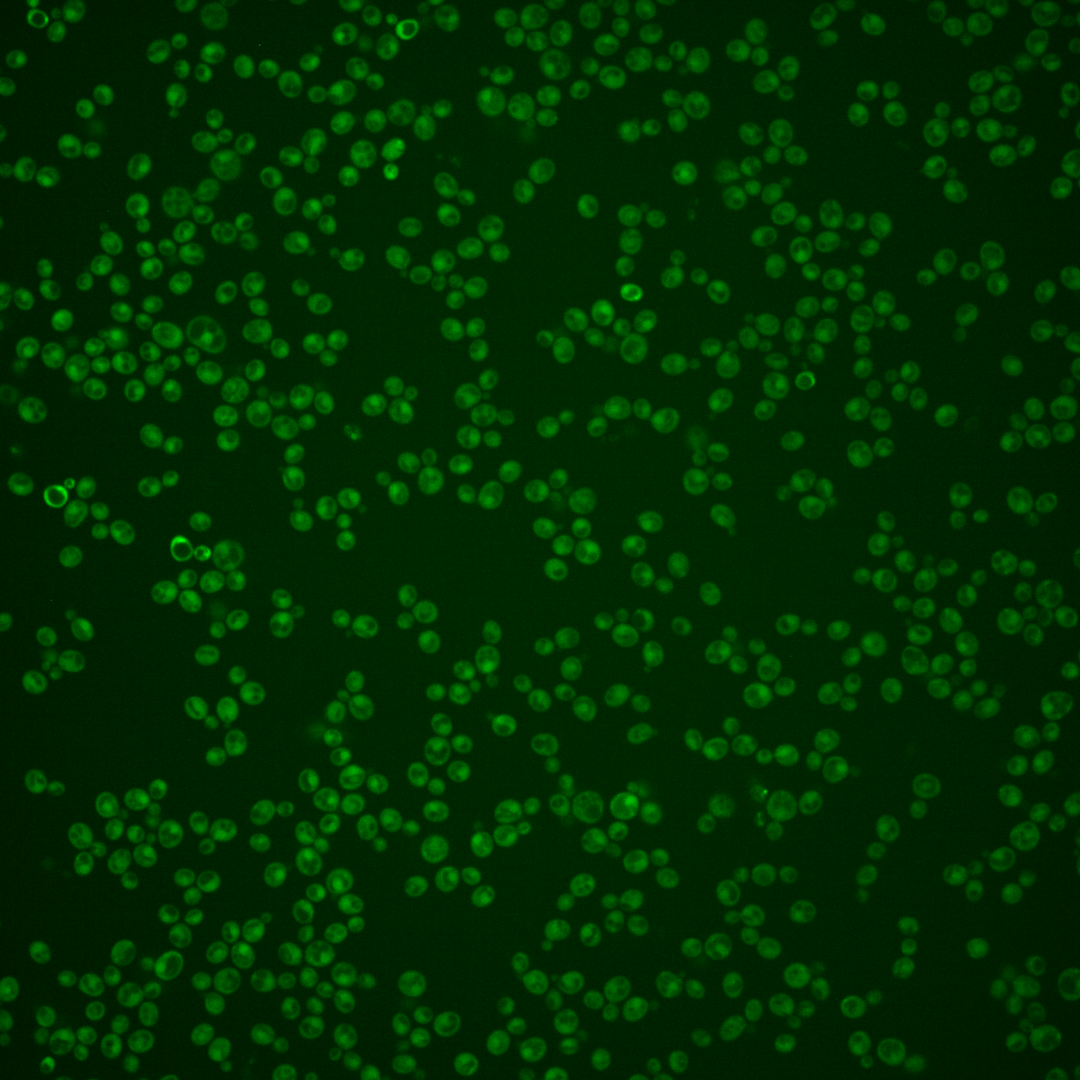

| ORF | |
|---|---|
| Human Ortholog | |
| Description | Putative protein of unknown function; expression is induced by activation of the HOG1 mitogen-activated signaling pathway and this induction is Hog1p/Pbs2p dependent; YJL107C and adjacent ORF, YJL108C are merged in related fungi |
Micrographs




















































































Sub-cellular Localization
Yeast GFP Assignment
Protein Abundance
Localization Change
External localization resources
| ensLOC | DeepLoc | |||||||||||||||||||||||
|---|---|---|---|---|---|---|---|---|---|---|---|---|---|---|---|---|---|---|---|---|---|---|---|---|
| Localization | WT1 | WT2 | WT3 | RAP60 | RAP140 | RAP220 | RAP300 | RAP380 | RAP460 | RAP540 | RAP620 | RAP700 | HU80 | HU120 | HU160 | rpd3Δ_1 | rpd3Δ_2 | rpd3Δ_3 | WT1 | WT2 | WT3 | AF100 | AF140 | AF180 |
| Cortical Patches | 0 | 0 | 0 | 0 | 0 | 0 | 0 | 0 | 0 | 0 | 0 | 0 | 0 | 0 | 0 | 0 | 0 | 0 | 3 | 2 | 6 | 1 | 0 | 5 |
| Bud | 0 | 0 | 0 | 1 | 3 | 4 | 16 | 15 | 14 | 12 | 18 | 24 | 0 | 0 | 0 | 0 | 0 | 0 | 0 | 0 | 1 | 6 | 1 | 10 |
| Bud Neck | 0 | 1 | 1 | 1 | 2 | 3 | 4 | 1 | 6 | 1 | 0 | 0 | 1 | 9 | 1 | 2 | 1 | 0 | 0 | 0 | 1 | 2 | 2 | 3 |
| Bud Site | 0 | 0 | 0 | 0 | 0 | 0 | 4 | 1 | 4 | 5 | 7 | 7 | 0 | 0 | 0 | 0 | 0 | 0 | – | – | – | – | – | – |
| Cell Periphery | 0 | 0 | 1 | 1 | 0 | 1 | 1 | 0 | 1 | 1 | 1 | 1 | 1 | 2 | 0 | 2 | 5 | 1 | 2 | 0 | 3 | 0 | 1 | 2 |
| Cytoplasm | 216 | 163 | 274 | 193 | 246 | 318 | 322 | 359 | 283 | 337 | 232 | 267 | 394 | 534 | 619 | 195 | 200 | 103 | 193 | 154 | 185 | 278 | 350 | 383 |
| Endoplasmic Reticulum | 2 | 0 | 1 | 0 | 1 | 0 | 0 | 1 | 0 | 0 | 0 | 0 | 0 | 2 | 0 | 10 | 11 | 10 | 2 | 1 | 3 | 0 | 0 | 4 |
| Endosome | 0 | 1 | 2 | 0 | 1 | 1 | 0 | 2 | 0 | 0 | 0 | 0 | 0 | 0 | 0 | 2 | 2 | 1 | 5 | 3 | 4 | 2 | 4 | 8 |
| Golgi | 0 | 1 | 2 | 0 | 0 | 0 | 0 | 0 | 0 | 0 | 0 | 0 | 0 | 0 | 1 | 1 | 0 | 1 | 0 | 1 | 3 | 1 | 0 | 2 |
| Mitochondria | 46 | 8 | 11 | 14 | 46 | 143 | 223 | 180 | 243 | 274 | 243 | 256 | 0 | 0 | 0 | 5 | 5 | 1 | 30 | 14 | 50 | 6 | 9 | 11 |
| Nucleus | 0 | 0 | 0 | 0 | 1 | 2 | 2 | 1 | 1 | 4 | 2 | 2 | 1 | 1 | 1 | 2 | 1 | 1 | 0 | 0 | 0 | 2 | 5 | 5 |
| Nuclear Periphery | 0 | 0 | 1 | 0 | 0 | 1 | 0 | 0 | 0 | 0 | 1 | 1 | 0 | 0 | 0 | 0 | 1 | 0 | 0 | 0 | 0 | 0 | 0 | 0 |
| Nucleolus | 0 | 0 | 0 | 0 | 1 | 1 | 0 | 1 | 1 | 0 | 2 | 0 | 0 | 0 | 0 | 0 | 0 | 0 | 0 | 0 | 0 | 0 | 0 | 0 |
| Peroxisomes | 0 | 0 | 0 | 0 | 1 | 0 | 0 | 1 | 0 | 0 | 0 | 0 | 0 | 0 | 0 | 0 | 1 | 0 | 0 | 0 | 0 | 0 | 0 | 0 |
| SpindlePole | 1 | 1 | 0 | 1 | 3 | 1 | 17 | 13 | 13 | 11 | 14 | 19 | 0 | 0 | 0 | 0 | 0 | 0 | 1 | 2 | 4 | 5 | 17 | 34 |
| Vac/Vac Membrane | 0 | 0 | 1 | 0 | 1 | 4 | 0 | 4 | 2 | 3 | 4 | 1 | 1 | 0 | 2 | 2 | 3 | 0 | 4 | 2 | 1 | 11 | 11 | 7 |
| Unique Cell Count | 239 | 171 | 285 | 198 | 267 | 392 | 448 | 475 | 449 | 495 | 387 | 440 | 397 | 537 | 622 | 203 | 210 | 107 | 252 | 185 | 277 | 329 | 413 | 491 |
| Labelled Cell Count | 265 | 175 | 294 | 211 | 306 | 479 | 589 | 579 | 568 | 648 | 524 | 578 | 398 | 548 | 624 | 221 | 230 | 118 | 252 | 185 | 277 | 329 | 413 | 491 |
Yeast GFP Assignment
Protein Abundance
| Screen | WT1 | WT2 | WT3 | RAP60 | RAP140 | RAP220 | RAP300 | RAP380 | RAP460 | RAP540 | RAP620 | RAP700 | HU80 | HU120 | HU160 | rpd3Δ_1 | rpd3Δ_2 | rpd3Δ_3 | AF100 | AF140 | AF180 |
|---|---|---|---|---|---|---|---|---|---|---|---|---|---|---|---|---|---|---|---|---|---|
| Mean Cell GFP Intensity (1e-4) | 2.7 | 3.8 | 3.7 | 3.5 | 3.5 | 2.7 | 2.8 | 2.9 | 2.5 | 2.4 | 2.3 | 2.3 | 4.8 | 4.7 | 4.5 | 5.2 | 5.2 | 4.9 | 5.0 | 4.8 | 5.3 |
| Std Deviation (1e-4) | 0.3 | 0.5 | 2.2 | 1.8 | 1.6 | 1.0 | 1.5 | 1.5 | 0.9 | 0.5 | 1.4 | 0.8 | 1.2 | 0.9 | 1.2 | 1.4 | 1.9 | 1.8 | 1.7 | 1.1 | 1.5 |
| Intensity Change (Log2) | – | – | – | -0.1 | -0.1 | -0.44 | -0.44 | -0.37 | -0.58 | -0.66 | -0.68 | -0.72 | 0.36 | 0.35 | 0.28 | 0.48 | 0.48 | 0.4 | 0.41 | 0.37 | 0.52 |
Localization Change
| Localization | RAP60 | RAP140 | RAP220 | RAP300 | RAP380 | RAP460 | RAP540 | RAP620 | RAP700 | HU80 | HU120 | HU160 | rpd3Δ_1 | rpd3Δ_2 | rpd3Δ_3 |
|---|---|---|---|---|---|---|---|---|---|---|---|---|---|---|---|
| Actin | – | – | – | – | – | – | – | – | – | – | – | – | – | – | – |
| Bud | – | – | – | – | – | – | – | – | – | – | – | – | – | – | – |
| Bud Neck | – | – | – | – | – | – | – | – | – | – | – | – | – | – | – |
| Bud Site | – | – | – | – | – | – | – | – | – | – | – | – | – | – | – |
| Cell Periphery | – | – | – | – | – | – | – | – | – | – | – | – | – | – | – |
| Cyto | – | – | – | – | – | – | – | – | – | – | – | – | – | – | – |
| Endoplasmic Reticulum | – | – | – | – | – | – | – | – | – | – | – | – | – | – | – |
| Endosome | – | – | – | – | – | – | – | – | – | – | – | – | – | – | – |
| Golgi | – | – | – | – | – | – | – | – | – | – | – | – | – | – | – |
| Mitochondria | – | – | – | – | – | – | – | – | – | – | – | – | – | – | – |
| Nuclear Periphery | – | – | – | – | – | – | – | – | – | – | – | – | – | – | – |
| Nuc | – | – | – | – | – | – | – | – | – | – | – | – | – | – | – |
| Nucleolus | – | – | – | – | – | – | – | – | – | – | – | – | – | – | – |
| Peroxisomes | – | – | – | – | – | – | – | – | – | – | – | – | – | – | – |
| SpindlePole | – | – | – | – | – | – | – | – | – | – | – | – | – | – | – |
| Vac | – | – | – | – | – | – | – | – | – | – | – | – | – | – | – |
| Cortical Patches | – | – | – | – | – | – | – | – | – | – | – | – | – | – | – |
| Cytoplasm | – | – | – | – | – | – | – | – | – | – | – | – | – | – | – |
| Nucleus | – | – | – | – | – | – | – | – | – | – | – | – | – | – | – |
| Vacuole | – | – | – | – | – | – | – | – | – | – | – | – | – | – | – |
External localization resources
Images






























Protein Concentration and Protein Localization Data
| R1 | R2 | R3 | ||||||||||||||||
|---|---|---|---|---|---|---|---|---|---|---|---|---|---|---|---|---|---|---|
| G1 Pre-START | G1 Post-START | S/G2 | Metaphase | Anaphase | Telophase | G1 Pre-START | G1 Post-START | S/G2 | Metaphase | Anaphase | Telophase | G1 Pre-START | G1 Post-START | S/G2 | Metaphase | Anaphase | Telophase | |
| Concentration | -1.5072 | -0.8557 | -1.2849 | -1.6206 | -1.2814 | -1.0267 | -0.904 | -0.8111 | -0.8675 | -1.0164 | 0.1512 | -1.023 | -1.2869 | -1.2188 | -1.091 | -0.1025 | -1.741 | -1.3681 |
| Actin | 0.0003 | 0 | 0.0003 | 0.0001 | 0.0002 | 0.0003 | 0.0359 | 0.0001 | 0.0141 | 0.017 | 0.0448 | 0.007 | 0.0299 | 0 | 0.0275 | 0.0634 | 0.0001 | 0.0081 |
| Bud | 0 | 0.0001 | 0.0006 | 0 | 0 | 0.0001 | 0.0032 | 0.0004 | 0.0019 | 0.002 | 0.0017 | 0.0003 | 0.0014 | 0 | 0.001 | 0.0013 | 0 | 0.0003 |
| Bud Neck | 0.0001 | 0 | 0.0001 | 0 | 0 | 0.0003 | 0.009 | 0 | 0.0063 | 0.0005 | 0.0025 | 0.0021 | 0.0014 | 0 | 0.0013 | 0.0052 | 0 | 0.001 |
| Bud Periphery | 0 | 0.0002 | 0.0002 | 0 | 0 | 0.0001 | 0.0083 | 0.0005 | 0.0039 | 0.0075 | 0.0052 | 0.0009 | 0.0033 | 0 | 0.0015 | 0.002 | 0.0001 | 0.0007 |
| Bud Site | 0.0001 | 0 | 0.0004 | 0 | 0 | 0 | 0.0164 | 0.003 | 0.005 | 0.0005 | 0.0045 | 0.0003 | 0.0059 | 0.0001 | 0.0056 | 0.0104 | 0 | 0.0011 |
| Cell Periphery | 0 | 0 | 0 | 0 | 0 | 0 | 0.0014 | 0.0001 | 0.0003 | 0.0002 | 0.0002 | 0.0001 | 0.0002 | 0 | 0.0002 | 0.0008 | 0 | 0.0001 |
| Cytoplasm | 0.0123 | 0.0114 | 0.0147 | 0.0058 | 0.0073 | 0.0201 | 0.0224 | 0.0298 | 0.0324 | 0.0418 | 0.019 | 0.0679 | 0.0353 | 0.0338 | 0.0552 | 0.0245 | 0.0702 | 0.0819 |
| Cytoplasmic Foci | 0.0054 | 0.001 | 0.003 | 0.0008 | 0.0012 | 0.0026 | 0.033 | 0.003 | 0.0096 | 0.0076 | 0.038 | 0.0079 | 0.0262 | 0.0012 | 0.0099 | 0.0133 | 0.003 | 0.0105 |
| Eisosomes | 0.0005 | 0.0001 | 0.0002 | 0.0001 | 0.0002 | 0.0001 | 0.0008 | 0.0001 | 0.0002 | 0.0002 | 0.0003 | 0.0002 | 0.0005 | 0.0001 | 0.0003 | 0.0007 | 0.0001 | 0.0001 |
| Endoplasmic Reticulum | 0.0002 | 0.0002 | 0.0001 | 0 | 0.0002 | 0.0002 | 0.0034 | 0.0004 | 0.0009 | 0.0008 | 0.0043 | 0.0007 | 0.0035 | 0.0002 | 0.0008 | 0.0031 | 0.0004 | 0.0037 |
| Endosome | 0.0005 | 0.0001 | 0.0002 | 0 | 0.0001 | 0.0002 | 0.012 | 0.0003 | 0.0061 | 0.0081 | 0.0585 | 0.0088 | 0.014 | 0.0001 | 0.0054 | 0.0491 | 0.0002 | 0.0056 |
| Golgi | 0.0001 | 0 | 0 | 0 | 0 | 0 | 0.0048 | 0 | 0.0039 | 0.0086 | 0.0179 | 0.004 | 0.0045 | 0 | 0.0051 | 0.0126 | 0 | 0.0015 |
| Lipid Particles | 0.0012 | 0.0001 | 0.0001 | 0 | 0.0002 | 0.0002 | 0.0107 | 0.0002 | 0.0022 | 0.0034 | 0.0154 | 0.0016 | 0.0149 | 0.0001 | 0.0033 | 0.0361 | 0.0003 | 0.0052 |
| Mitochondria | 0.0002 | 0.0001 | 0.0001 | 0 | 0.0001 | 0.0001 | 0.0055 | 0.0002 | 0.0024 | 0.015 | 0.013 | 0.0099 | 0.0066 | 0 | 0.0052 | 0.0081 | 0.0001 | 0.0016 |
| None | 0.9743 | 0.9862 | 0.9737 | 0.9928 | 0.9891 | 0.9686 | 0.7907 | 0.96 | 0.8912 | 0.856 | 0.7026 | 0.8793 | 0.8212 | 0.9634 | 0.8671 | 0.6945 | 0.9236 | 0.8567 |
| Nuclear Periphery | 0.0002 | 0.0001 | 0.0001 | 0 | 0.0004 | 0.0003 | 0.0084 | 0.0003 | 0.0013 | 0.001 | 0.0281 | 0.0008 | 0.0034 | 0.0001 | 0.0008 | 0.0201 | 0.0002 | 0.0062 |
| Nucleolus | 0.0004 | 0 | 0.0003 | 0 | 0.0001 | 0.0002 | 0.0011 | 0.0002 | 0.0009 | 0.0004 | 0.0008 | 0.0003 | 0.0006 | 0 | 0.0003 | 0.0026 | 0.0001 | 0.0022 |
| Nucleus | 0.0006 | 0.0001 | 0.0009 | 0.0001 | 0.0003 | 0.0009 | 0.0042 | 0.0004 | 0.0018 | 0.001 | 0.0041 | 0.0012 | 0.0023 | 0.0005 | 0.0013 | 0.0206 | 0.0006 | 0.003 |
| Peroxisomes | 0.0003 | 0 | 0.0002 | 0 | 0.0001 | 0.0001 | 0.0169 | 0.0001 | 0.0076 | 0.0239 | 0.0223 | 0.0019 | 0.0157 | 0 | 0.003 | 0.0061 | 0.0001 | 0.002 |
| Punctate Nuclear | 0.003 | 0.0001 | 0.0047 | 0.0002 | 0.0005 | 0.0054 | 0.0051 | 0.0005 | 0.0066 | 0.0014 | 0.011 | 0.004 | 0.0072 | 0.0002 | 0.0045 | 0.0137 | 0.0005 | 0.0065 |
| Vacuole | 0.0001 | 0.0001 | 0.0001 | 0 | 0.0001 | 0.0001 | 0.0048 | 0.0004 | 0.0011 | 0.0016 | 0.0027 | 0.0004 | 0.0014 | 0.0001 | 0.0006 | 0.0092 | 0.0001 | 0.0013 |
| Vacuole Periphery | 0 | 0 | 0 | 0 | 0 | 0 | 0.0021 | 0.0001 | 0.0003 | 0.0014 | 0.003 | 0.0004 | 0.0006 | 0 | 0.0002 | 0.0028 | 0 | 0.0006 |
Sequencing Data
| R1 | R2 | |||||||||
|---|---|---|---|---|---|---|---|---|---|---|
| G1 Post-START | S/G2 | Metaphase | Anaphase | Telophase | G1 Post-START | S/G2 | Metaphase | Anaphase | Telophase | |
| Gene Expression | 2.8438 | 2.5422 | 1.8864 | 5.0673 | 3.0726 | 4.7371 | 4.4982 | 2.3131 | 5.5844 | 6.602 |
| Translational Efficiency | – | – | – | – | – | – | – | – | – | – |
Hit Data
| Dataset | Hit |
|---|---|
| Protein Concentration | ✘ |
| Protein Localization | ✘ |
| Gene Expression | ✘ |
| Translational Efficiency | – |
Endocytosis
| Temp | Actin Patch (Sac6-tdTomato) | Cortical Patch (Sla1-GFP) | Late Endosome (Snf7-GFP) | Vacuole (Vph1-GFP) |
|---|---|---|---|---|
| 37℃ | ||||
| RT |
Cell Cycle Omics
CYCLoPs (Yjl107c-GFP)
| Gene / Allele | Actin Patch (Sac6-tdTomato) | Cortical Patch (Sla1-GFP) | Late Endosome (Snf7-GFP) | Vacuole (Sac6-tdTomato) |
|---|
| Gene | Images |
|---|
| Gene | Images |
|---|
Images are not yet available
Images are not yet available